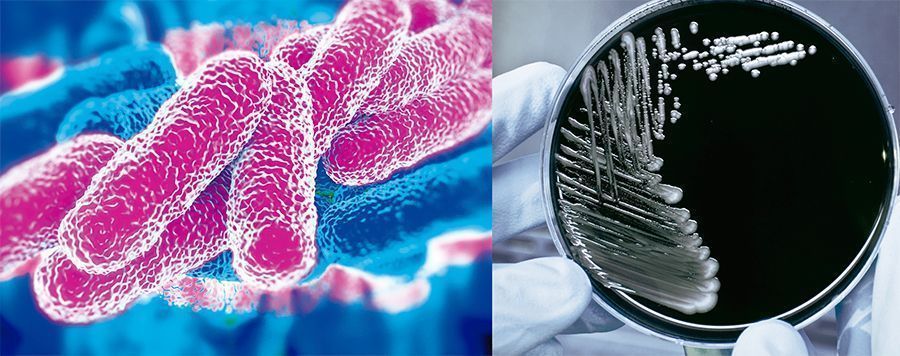
fondo legp6 1

La Asociación Nacional de Empresas de Sanidad Ambiental (ANECPLA) insiste en la vital importancia de realizar un adecuado mantenimiento de las torres de refrigeración, llevado a cabo por técnicos expertos.
Los casos de legionelosis registrados en Europa desde el año 2011 a 2015 han ido progresivamente en aumento, al menos 450 personas mueren anualmente a consecuencia de esta enfermaded. Así lo ha hecho patente un informe que acaba de hacer público el European Center for Desease Control (ECDC). En este repunte de casos registrados de Legionella, España vuelve a situarse entre los países a la cabeza de Europa, junto con Alemania, Italia y Francia.
En estos 5 años, 29 países notificaron al ECDC un total de 30.532 casos de legionelosis. Algo más del 70% de ellos se produjeron en Alemania, España, Francia o Italia (a pesar de que la población combinada de estos 4 países apenas llega a la mitad de la población total estudiada). Más de un millar de personas se ven afectadas por la bacteria de la Legionella en España al año.
Por sexos, generalmente la enfermedad afecta más a hombres que a mujeres y el número de casos aumenta, además, con la edad. De hecho, prácticamente un 80% de todos los casos se produjeron en personas de más de 50 años.
Con respecto al origen de la enfermedad, la mayor parte de ellas (hasta el 70%) fueron adquiridas en la comunidad, mientras que el 30% restante se divide entre casos asociados a viajes (casi un 20%), las contraídas en centros sanitarios (7,3%) y otro tipo de instalaciones (2%).
Nueva Norma UNE 100030, destinada a reducir los casos de Legionella en España
El pasado mes de abril entró en vigor, en sustitución de la anterior de 2005 que cita el Real Decreto 865/2003, la actualización de la Norma UNE 100030:2017, en cuya redacción ha colaborado la Asociación Nacional de Empresas de Sanidad Ambiental (ANECPLA). Esta nueva norma viene a proporcionar criterios y orientaciones para la prevención y el control de la proliferación y diseminación de la Legionella a partir de ciertas instalaciones y equipos, con un alcance mucho más completo que la anterior, abordando en sus 116 páginas nuevos procedimientos y protocolos de trabajo actualizados para las 14 principales instalaciones de riesgo, actuaciones según los resultados analíticos de control por instalación, requerimientos voluntarios de la solvencia técnica de las empresas de servicios, y otra serie de indicaciones y procedimientos que acotan y precisan con mayor exactitud el marco preventivo y de control de la Legionella.
Se trata de un instrumento de gran utilidad para los titulares de las instalaciones, laboratorios, empresas de mantenimiento y tratamiento de agua, así como empresas de servicios a terceros e ingenierías y consultores, entre otros, destinado a reducir activamente los casos de Legionella en España.
ANECPLA recomienda
Desde ANECPLA, se insiste en extremar los controles para impedir la propagación de la bacteria a partir de medidas como las que se exponen a continuación:
- Evitar las condiciones ambientales que favorezcan la colonización, multiplicación y dispersión de Legionella. Estas son: temperaturas entre 25-45ºC (adecuadas para su crecimiento), estancamiento de agua y acumulación de sustratos o productos que puedan servir de alimento.
- Limpiezas y desinfecciones, en particular antes de la puesta en marcha de una instalación tras haberla tenido parada. El control de la misma es la principal medida de prevención, muy especialmente en lo referente a hospitales, centros médicos y clínicas.
- Acudir a empresas profesionales y autorizadas para la realización de ese mantenimiento.
- El cumplimiento de la normativa por parte de propietarios y usuarios y el incremento de medidas cautelares son otros dos aspectos prioritarios. De esta manera podremos evitar futuros brotes que pongan en riesgo la salud de las personas.
Guía para la contratación de servicios de higienización y control de Legionella
ANECPLA dispone de una Guía para la contratación de servicios de higienización y control de Legionella cuyo objetivo es ayudar a los responsables de la contratación del servicio proporcionándoles los criterios mínimos que han de cumplir este tipo de empresas a fin de que puedan valorar, con conocimiento de causa, las distintas ofertas entregadas por las empresas de control de plagas.
La Guía ha sido llevada a cabo por un equipo de trabajo conformado por profesionales del sector de distintos ámbitos como son empresas de tratamiento, laboratorios, consultores, técnicos de mantenimiento, fabricantes de biocidas y representantes de la Administración Pública. Y los criterios que esta Guía contempla pasan por determinar las características y requisitos básicos en cuanto al responsable técnico, el personal técnico cualificado, los productos permitidos, la Ley de Prevención de Riesgos Laborales al respecto, las características del laboratorio de análisis, etc. Todo ello en aras de un único objetivo, que no es otro que garantizar un correcto mantenimiento de las instalaciones que no ponga en riesgo en ningún momento la salud de las personas.
Sobre la Legionella
La Legionella es una bacteria que se encuentra en el agua, ya sea de manera natural o artificial. Con un total de 48 especies enmarcadas dentro de este género, es la Legionella pneumóphila la que produce la legionelosis, enfermedad que se presenta como una neumonía con fiebre alta, con una incidencia de 3 casos por 100.000 habitantes en España, lo que supone unos 1000 casos al año.
La Legionella se encuentra en su medio natural en bajas concentraciones. Sin embargo, en instalaciones que favorecen el estancamiento de agua y acumulación de productos que puedan servir de nutrientes para la bacteria y con una temperatura propicia para su supervivencia y proliferación, puede provocar la multiplicación de la bacteria hasta concentraciones infectantes para el ser humano.
Dado que la Legionella Pneumophila suele sobrevivir en espacios húmedos, instalaciones como torres de refrigeración, sistemas de distribución de agua caliente sanitaria o condensadores evaporativos son considerados como potenciales amplificadores de Legionella. De ahí que espacios como residencias u hospitales sean especialmente sensibles a la proliferación de la bacteria y deban, por tanto, extremar las precauciones.
La Legionella entraña un riesgo real para las personas, sobre todo para aquellas que superen la edad de los sesenta años, fumadores o con un sistema inmunológico debilitado.
El contagio puede producir una infección pulmonar caracterizada por neumonía con fiebre alta, aunque también puede presentarse en forma no neumónica como ‘’Fiebre de Pontiac’’, que se manifiesta como un síndrome febril agudo.



Los casos de legionelosis registrados en el periodo de 2011 a 2015, objeto del estudio, aumentaron a 1,30 casos por 100.000 habitantes, el número más elevado hasta la fecha